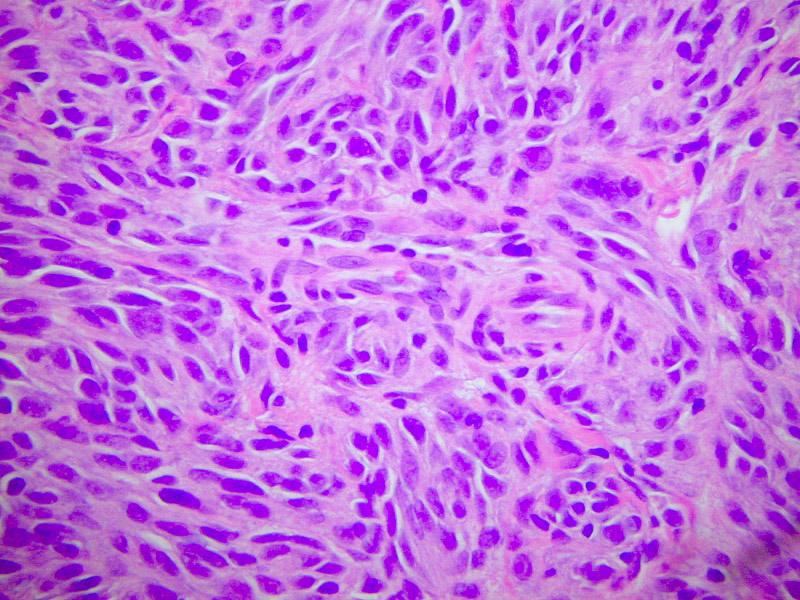

|
Laboratoriet for Klinisk Patologi och Cytologi, Södra Älvsborg Sjukhus Boras, Szwecja Płeć: żeńska, wcześniej zdrowa, Wiek: 16 lat Ze strony ojca w bliskiej rodzinie częste nowotwory, również w wieku dziecięcym (osteosarcoma). Od dwóch miesięcy powoli rosnący, niebolesny, ruchomy węzeł w okolicy prawego kąta żuchwy 1,5 cm średnicy. W kontroli stomatologicznej wykryto w błonie śluzowej policzka po stronie prawej owalną, lekko, nierównomiernie wyniesioną zmianę, 2,0 x 1,5 cm, w kolorze śluzówki, bez owrzodzenia. Pacjentka łączyła zmianę z ugryzieniem ok. 2 miesięcy wcześniej i nie przywiązywała do niej wagi. Materiał z biopsji cienkoigłowej węzła szyjnego (wykonanej przez klinicystę dwukrotnie) był zbyt skąpy do oceny. Do badania nadesłano wycinek ze zmiany (incision biopsy) w śluzówce policzka prawego. |

| (HE 100x) Błona śluzowa jamy ustnej z naciekiem melanoma malignum (od prawej) i reaktywnym rozrostem nabłonka płaskiego (po lewej). |
|
(HE
400x) Naciek melanoma złożony z wrzecionowatych komórek o
niewielkim polimorfizmie. |

|
(HE 100x) Przerzut czerniaka (od prawej) do węzła chłonnego (od lewej). |

|
(CKMNF 200x) Reakcja dla cytokeratyn o szerokim spektrum (CK MNF) – widoczne silne zabarwienie naskórka (u góry) i brak zabarwienia w komórkach nowotworowych (u dołu). |

|
(S100 200x) Silne dodatnia reakcja dla białka S-100 w komórkach czerniaka. |

|
(HMB-45
200x) Silnie dodatnia reakcja dla HMB-45 w komórkach
czerniaka.
Amelanotyczny czerniak złośliwy jamy ustnej u 16-latki
Przedstawiamy przypadek niezwykle rzadkiego pierwotnego wystąpienia amelanotycznego czerniaka złośliwego w jamie ustnej u 16 letniej dziewczyny.
Pacjentka wcześniej nie chorowała. Nie obserwowano ani u niej samej, ani u bliskiej rodziny występowania czerniaka lub nietypowych zmian barwnikowych. Od strony ojca w bliskiej rodzinie częste nowotwory (bliżej nieznane), również w wieku dziecięcym (osteosarcoma). Powodem zgłoszenia się do lekarza był od dwóch miesięcy powoli rosnący, niebolesny, ruchomy węzeł w okolicy prawego kąta żuchwy, 1,5 cm średnicy. Materiał z biopsji cienkoigłowej węzła szyjnego (wykonanej przez klinicystę dwukrotnie) był zbyt skąpy do oceny. W zaleconej konsultacji stomatologicznej wykryto w błonie śluzowej policzka po stronie prawej za zębami trzonowymi owalną, lekko, nierównomiernie wyniesioną zmianę, 2,0 x 1,5 cm, w kolorze śluzówki, bez owrzodzenia. Pacjentka łączyła zmianę z ugryzieniem ok. 2 miesięcy wcześniej i nie przywiązywała do niej wagi. Klinicznie zmiana nie nasuwała podejrzenia nowotworu złośliwego. Ze względu na duże rozmiary zmiany, w celu zaplanowania zabiegu, pobrano przedoperacyjnie wycinek histologiczny (incision biopsy) oraz pobrano do badania węzeł chłonny. Mikroskopowo: naciek nowotworowy w śluzówce o dość monotonnym wyglądzie, zbudowany głównie z komórek wrzecionowatych z cechami atypii średniego stopnia i jedynie ogniskowo zwiększoną liczbą mitoz (1-2/10 HPF). W części jąder komorkowych obecne wyraźne centralne jąderka. Komórki tworzą nieregularne, krzyżujące się pasma. Brak martwicy. Nabłonek ponad zmianą z cechami akantotycznego, reaktywnego rozrostu. Komórki zmiany dochodzą odcinkowo do granicy z nabłonkiem jednak go nie obejmują. Ogniskowo na granicy z nabłonkiem obecne są nieliczne komórki o epitelioidnym wyglądzie, w części wielojądrzaste. W badaniach immunohistochemicznych komórki nowotworowe nie zawierały antygenów nabłonkowych (CK MNF, AE1/AE3) oraz naczyniowych (CD 34, FVIII). Silnie dodatnie reakcje uzyskano dla S-100, HMB-45 i wimentyny. Reakcja z Melan A była ujemna. W węźle chłonnym szyjnym stwierdzono rozlegle przerzuty nowotworowe o takim samym obrazie histologicznym jak zmiana w śluzówce. Naciek nie obejmował torebki węzła. Na podstawie cech morfologicznych, a zwłaszcza w oparciu o profil immunohistochemiczny, w rozpoznaniu różnicowym uwzględniono głównie dwie jednostki: pierwotny lub przerzutowy czerniak złośliwy jamy ustnej lub mięsak jasnokomórkowy sarcoma clarocellulare (również zwany czerniakiem tkanek miękkich). W zaleconych szerokich badaniach konsultacyjnych nie wykryto ewentualnego innego ogniska pierwotnego. Pacjentka została skierowana do ośrodka chirurgii onkologicznej Sahlgrenska Universitet w Göteborgu, gdzie wykonano radykalne wycięcie zmiany w jamie ustnej oraz lymfadenektomię szyjną po stronie prawej. W jednym z węzłów chłonnych stwierdzono drobne ogniska przerzutowe. Badanie genetyczne (prof.G.Stenman) z nowo pobranego materiału nie wykazało obecności w nowotworze typowej (ponad ¾ przypadków) dla sarcoma clarocellulare translokacji t(12;22)(q13;q12) (za Goldblum i Weiss, 2001). W związku z tym rozpoznanie końcowe brzmi: pierwotny amelanotyczny czerniak złośliwy jamy ustnej z przerzutami do węzłów chłonnych szyi. Badanie było konsultowane przez prof. L-G.Kindblom i prof J.Meis-Kindblom, Sahlgränska Universitetssjukhuset Göteborg.
WYSTĘPOWANIE I OBRAZ KLINICZNY
Częstość występowania czerniaków błon śluzowych jest w dużym stopniu uwarunkowana geograficznie. W USA (D’Silva i wsp. 2002) czerniaki śluzówkowe stanowią ok. 2% wszystkich czerniaków. Około połowa występuje w obrębie głowy i szyi. Czerniak jamy ustnej pojawia się z czestością 1,2/10 000 000 mieszkańców na rok i stanowi 0,05 % złośliwych guzów nowotworowych jamy ustnej. W Europie zapadalność jest podobna. W Japonii, gdzie czerniaki generalnie są rzadsze niż w populacji europejskiej, pierwotny czerniak jamy ustnej jest relatywnie częstszy i stanowi 12 % wszystkich melanoma.
Choroba występuje częściej u mężczyzn i zwykle po 40 roku życia. Gro opisywanych przypadków dotyczy osób po 70 roku życia. Pediatryczne (poniżej 18 roku życia) przypadki czerniaka jamy ustnej pojawiają się sporadycznie w literaturze światowej i ich liczba nie przekracza 10. Najmłodszy pacjent z melanoma in situ miał 3 miesiące (Ovens i wsp. 2001) . W jednym przypadku melanoma in situ w jamie ustnej rozpoznano u 16 latka z zespołem znamion dysplastycznych (Tremblay i wsp. 2000). 20% czerniaków rozpoznanych w jamie ustnej ma charakter przerzutowy (za Smyth i ws. 1993)
Około 1/3 czerniaków jamy ustnej powstaje na podłożu zmian barwnikowych określanych jako melanosis, lentigo, czy atypical lentigo. 75 % czerniaków jamy ustnej powstaje w obrębie szczęki i dotyczy podniebienia i górnych dziąseł. Zmiana może mieć charakter płaskiego, niesymetrycznego przebarwienia, może być wyniesiona, polipowata, melanotyczna, rzadziej amelanotyczna, z lub bez owrzodzenia. W bardziej zaawansowanych zmianach dochodzi do destrukcji kości wyrostka zębodołowego z rozluźnieniem zębów.
OBRAZ MIKROSKOPOWY
Większość czerniaków jamy ustnej przypomina czerniaki skórne typu acral-lentiginous malignant melanoma i jest zbudowana z względnie mononomorficznych wrzecionowatych lub dendrytycznych melanocytów. Obraz przypomina wrzecionowatokomórkowego mięsaka. Komórki nowotworowe mają zwykle kontakt z nabłonkiem, jednak pagetoidne naciekanie nabłonka występuje rzadko i nie jest generalnie charakterystyczne dla czerniaków śluzówkowych. Druga forma czerniaka, najczęściej widywana w śluzówkach, jest odpowiednikiem skórnego nodular melanoma i nie jest poprzedzona fazą radialną. Może być zbudowana zarówno z wrzecionowatych , jak i epitelioidnych melanocytów. W jamie ustnej stwierdza się też, szczególnie trudnego diagnostycznie, czerniaka desmoplastycznego i neurotropowego (Kilpatrick i wsp. 1996). W części przypadków czerniaka jamy ustnej obserwuje się reaktywne pseudoepitelomatyczne rozrosty nabłonka płaskiego. Częściej niż w postaciach skórnych, stwierdza się w pierwotnych czerniakach śluzowkowych inwazję naczyń - w 25% (Prasad i wsp. 2002). Zdecydowanie rzadziej (2-10%) niż w skórze (30%) stwierdza się w jamie ustnej czerniaka amelanotycznego.
OMÓWIENIE I DIAGNOSTYKA RÓŻNICOWA
Czerniaki złośliwe błon śluzowych występują w okolicy okołoodbytowej, sromie, pochwie, jamie nosowej, spojówce i w jamie ustnej. Czerniaki w błonach śluzowych stanowią odrębną grupę, różniącą się biologią i prognozą od skórnych odpowiedników Czerniaki złośliwe jamy ustnej są niezwykle rzadkie. Dotyczy to zwłaszcza form amelanotycznych, które w okresie pediatrycznym (do 18 roku życia) stanowią kazuistykę w skali światowej. W dostępnym piśmiennictwie znaleźliśmy jedynie jeden współcześnie udokumentowany przypadek amelanotycznego melanoma w tej grupie wiekowej (D’Silva i wsp. 2002). Opisany przez autorów melanoma jamy ustnej u 17 letniej dziewczyny pochodzenia azjatyckiego miał bardzo zbliżoną budowę histologiczną do przedstawianego przez nas przypadku. W porównaniu z odpowiednikami skórnymi, czerniak jamy ustnej zwykle jest diagnozowany w stanie bardziej zaawansowanym, tj.: większa grubość zmian i częstsza obecność przerzutów do węzłów chłonnych lub przerzutów odległych w momencie ustalenia rozpoznania (50%). Ze względu na mniej widoczną lokalizację, zmiany wykrywane są później. Poza tym, z racji rzadkości, droga do właściwego rozpoznania często jest zawiła. W opisywanych w literaturze przypadkach często pierwotnie błędnie rozpoznawano różne typy mięsaków, niezróżnicowanego raka, raka płaskonabłonkowego lub nawet zmiany łagodne typu epulis (Notani i wsp. 2002). W zależności od budowy poszczególnego guza, w diagnostyce różnicowej bierze się pod uwagę różne typy zmian. Np. dla płaskich czerniaków melanotycznych: znamiona barwnikowe, melanoacanthoma, lentigo simplex, tatuaż amalgamatowy; dla wyniosłych czerniaków amelanotycznych: mięsaki (zwłaszcza sarcoma clarocellulare o podobnym profilu immunohistochemicznym), nisko zróżnicowane, wrzecionowatokomórkowe raki, bogatokomórkowe guzy łagodne: np. schwannoma cellulare, epulis fibrosa, palisaded neuroma. W badaniach dodatkowych: barwieniem na melaninę metodą Masson-Fontana można potwierdzić rodzaj pigmentu w guzach zawierających barwnik. W diagnostyce, zwłaszcza form ubogo- lub amelanotycznych, dużą rolę odgrywają badania immunohistochemiczne. Białko S-100 występuje w 97%, HMB-45 w 71% i Melan A w 74% czerniaków jamy ustnej (Prasad i wsp. 2001). Również stwierdzenie w mikroskopie elektronowym obecności premelanosomów lub melanosomów może mieć rozstrzygające znaczenie w ustaleniu rozpoznania. Chu i wsp.1993 opisują niskozróżńicowany guz jamy ustnej pozytywny dla S-100, bez melanosomów w mikroskopie elektronowym, który w ogniskach przerzutowych wytwarzał melaninę.
Prasad i wsp. 2002 badali wpływ dziesięciu typowych parametrów morfologicznych na rokowanie w czerniaku śluzówkowym głowy i szyi. Stwierdzili oni znamienne pogorszenie rokowania w analizie jednoczynnikowej dla trzech parametrów: znaczny polimorfizm komórkowy, inwazja naczyniowa i obecność martwicy. Klasyczne parametry prognostyczne dla czerniaka skórnego jak: poziom inwazji według Clarka, obecność owrzodzenia, średnica guza, przerzuty do regionalnych węzłów chłonnych - nie mają znamiennie istotnego znaczenia w rokowaniu w czerniaku jamy ustnej. Wedlug Prasad i wsp. 2002 większa grubość guza wg Breslowa nie ma istotnego statystycznie wpływu na prognozę, jednak w innych opracowaniach wpływa na skrócenie przeżywalności (za Smyth i wsp. 1993).
Czerniaki jamy ustnej mają gorsze rokowanie niż odpowiedniki skórne (Barrett i wsp. 1995), a ponandto formy amelanotyczne są bardziej agresywne niż melanotyczne (Notani i wsp. 2002). Według pojedynczych doniesień, gorsza prognoza w nie dotyczy czerniaków jamy ustnej w pediatrycznej grupie wiekowej, gdzie nawet nieradykalnie usunięte zmiany mogą mieć zaskakująco długotrwały przebieg (za Owens i wsp. 2002). Obserwacje te opierają się jednak na pojedynczych przypadkach i nie mogą być zweryfikowane statystycznie.
PIŚMIENNICTWO
Barrett, A.W., Bennett, J.H., Speight, P.M.: A clinicopathological and immunohistochemical analysis of primary oral mucosal melanoma. Oral Oncol Eur J Cancer 31:100-105, 1995.
Chu, L., Abdul, A., Takahashi, T., Koijima, A., Himiya, T., Kusama, K., Komiyama, K., Hori,M., Matsumoto, M., Tanaka, H., Moro, I.:Amelanotic melanoma of oral cavity. J Nihon Univ Sch Dent 35:124-129, 1993.
Goldblum, J.R., Weiss, S.W.: Soft tissue tumours. Mosby, 2001.
Kilpatrick, S.E., White, W.L., Browne, J.D.: Desmoplastic malignant melanoma of the oral mucosa. An underrecognized diagnostic pittfal. Cancer 78:383-389, 1996.
Notani, K., Shindoh, M., Yamazaki, Y., Nakamura, H., Watanabe, M., Kogoh, T., Ferguson, M.M.Fukuda, H.: Amelanotic malignant melanomas of the oral mucosa. Br J Oral Maxillofac Surg 40:195-200, 2002.
Odell, E.W., Morgan, P.R.: Biopsy Pathology of the Oral Tissues. Chapman and Hall Medical, 1998.
Owens J.M., Gomez, J.A., Bayers, R.M.: Malignant melanoma in the palate of a 3-month child. Head Neck 24:91-94, 2002
Prasad, M.L., Jungbluth, A.A., Iversen, K., Huvos, A.G., Busam, K.J.: Expression of melanocytic differentiation markers in malignant melanomas of the oral sinonasal mucosa. A J Surg Pathol 25:782-787, 2001.
Prasad, M.L., Patel, S., Hoshaw-Woodard, S., Escrig, M., Shah, J.P., Huvos Busam K.J.: Prognostic factors for malignant melanoma of the squamous mucosa of the head and neck. Am J Surg Patol 26:883-892, 2002.
Smyth, A.G., Ward-Booth, R.P., Avery, B.S., To, E.W.H.: Malignant melanoma of the oral cavity – an increasing clinical diagnosis? Br J Oral Maxiofac Surg 31:230-235, 1993.
Tremblay, J-F.O’Brien, E.A., Chauvin, P.J.: Melanoma in situ of the oral mucosa in an adolescent with dysplastic nevus syndrome. J Am Acad Dermatol 42:844-6, 2000.
Umeda, M., Komatsubara, H., Shibuya, Y., Yokoo, S., Komoro, T.: Premalignant melanocytic dysplasia and malignant melanoma of the oral mucosa. Oral Oncology 38:714-722, 2002. |